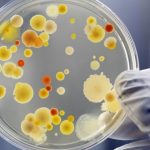

Fransız ve Amerikalı uzmanların yaptığı araştırmalara göre, sindirim sistemimizin derinliklerinde yaşayan bakteriler, kanser tedavisi sırasında tümörlerin büyüyüp küçülmesinde etkili oluyor.
Araştırmalarda, kanser hastalarındaki mikrobiyomlar, yani içimizde yaşayan mikroskobik organizmalar incelendi.
mikroskobik organizmalar incelendi.
Science dergisinde yayımlanan iki çalışmada, belirli bakteri türleri ve genel anlamda mikrobiyom çeşitliliğinin, bağışıklık sistemi harekete geçiren tedavilerde kullanılan immunoterapi ilaçları üzerindeki etkilerine bakıldı.
Vücudumuzda trilyonlarca mikro organizma yaşıyor ve bizimle aralarındaki ilişki aslında enfeksiyon hastalıklarının çok ötesine gidiyor.
Mikrobiyomlar sindirimde, enfeksiyondan korunmada ve bağışıklık sisteminin düzenlenmesinde rol oynuyor.
Her iki çalışmada da, vücudun tümörlerle savaştaki kendi savunma mekanizmasını güçlendiren immunoterapi tedavisi gören hastalar incelendi.
İmmunoterapi her hastada işe yaramıyor ancak bazı vakalarda ölümcül aşamaya gelen tümörler bile temizlenebiliyor.
İyi ve kötü bakteri karışımları
Paris’teki Gustave Roussy Kanser Kampüsü’nde yapılan bir çalışmada, böbrek veya akciğer kanseri teşhisi konulmuş 249 hasta incelendi.
Araştırma sonucu, örneğin dişlerindeki bir apse için antibiyotik alan hastaların, mikrobiyomlarına zarar verdikleri ve immunoterapi tedavisi görürken tümörlerinin büyüme ihtimalinin daha büyük olduğu sonucuna varıldı.
Özellikle bir bakteri türü Akkermansia muciniphila tedaviye yanıt veren hastaların yüzde 69’unda bulunuyordu. Bu bakteri, tedaviye yanıt vermeyenlerin ise sadece üçte birinde vardı.
Farelerde yapılan testlerde A. muciniphila seviyesi arttırılanların, immunoterapiye daha iyi verdikleri tespit edildi.
Bu arada, Teksas Üniversitesi Kanser Merkezi’nde incelenen, ilerlemiş habis tümörlere sahip 112 hastanın mikrobiyomları incelendi.
Daha zengin ve büyük çeşitliliğe sahip mikrobiyomları olanların, olmayanlara kıyasla tedaviye daha iyi yanıt verdiği görüldü.
Yüksek düzeyde FaecalibacteriumveClostridialesadlı bakterilerin işe yaradığı ancak Bacteroidales‘invarlığının iyi gelmediği gözlendi.
Doku örnekleri incelenince de, yararlı bakterilere sahip hastaların tümörlerinde daha çok kanserli hücre öldüren bağışıklık sistemi hücresi bulunduğu tespit edildi.
Daha sonra insan dışkısındaki madde, kanser tümörleri bulunan farelere nakledildi.
“İyi” bakteri karışımına sahip hastaların dışkısının tranfer edildiği farelerin tümörlerindeki büyümenin, kötü bakteri transfer edilen farelere kıyasla daha yavaş olduğu gözlendi.
Teksas’taki araştırmayı yapan ekipten Dr Jennifer Wargo, BBC’ye yaptığı açıklamada, “Bir hastanın mikrobiyomunu bozarsanız, kanser tedavisine yanıt verme kabiliyetini bozabilirsiniz. Bizim teorimiz, hastanın mikrobiyomunu daha iyi olacak şekilde yeniden düzenlerseniz, tedaviye daha iyi yanıt verebilir şeklinde” dedi.













